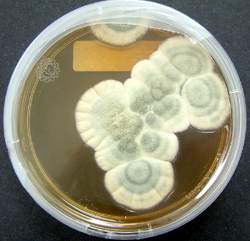

Cú hắt hơi kỳ diệu
Thật khó tin, nhưng quả thật ngay từ đầu thế kỷ trước, thậm chí ở những nước phát triển nhất, tính trung bình, con người chỉ sống tới 40 tuổi. Tỷ lệ tử vong khủng khiếp của trẻ em, các bệnh dịch từng cướp đi sinh mạng của cả một khu vực dân cư rộng lớn, những trận đánh ác liệt mà sau đó, thậm chí những vết thương tương đối nhẹ cũng gây nên nhiễm trùng máu vô phương cứu chữa.
Tình hình này cứ tiếp diễn như vậy cho đến khi nhà vi trùng học Anh quốc Alexander Fleming (1881-1955) một hôm, do bị cảm lạnh, đã vô tình hắt hơi vào chiếc bát sứ đang nuôi cấy vi khuẩn trong phòng thí nghiệm của ông...
Mấy ngày sau đó, một điều kỳ lạ đã xảy ra. Sau khi ngó nhìn vào cái bát vốn là nạn nhân của cú hắt hơi vô tiền khoáng hậu nọ, Fleming nhận thấy sự sản sinh của vi khuẩn đã dừng lại. Bằng cảm quan nhạy bén hiếm có của nhà khoa học, ông hiểu ngay rằng trong tiết nhày của con người có những chất đã kìm hãm sự phát triển của các loại vi khuẩn gây bệnh.
Vào thời gian đó, các thầy thuốc cho rằng nhiệm vụ chủ yếu trong cuộc đấu tranh chống lại bệnh tật là tạo ra những thứ thuốc có khả năng củng cố cơ thể. Chỉ có một số ít người tìm kiếm những chất chống lại chính bản thân căn bệnh mà thôi. Fleming không thuộc về số những người đó. Cũng như đa số đồng nghiệp, ông nhìn thấy việc giải quyết mọi vấn đề y tế ở miễn dịch học.
![]() |
Alexander Fleming |
Cuộc Chiến tranh thế giới lần thứ nhất (1914-1918) nổ ra. Với quân hàm đại úy quân y trong quân đội Hoàng gia, ông đã chiến đấu ở Pháp. Ông không chỉ điều trị mà còn cầm súng, còn xông lên tấn công. Nhưng trước hết, ông là một bác sĩ. Tại đó, trên chiến trường, ông hiểu rằng cần phải chữa bệnh không chỉ bằng cách cố thủ trong pháo đài mà còn phải bằng cách tích cực tiêu diệt địch. Cách phòng vệ tốt nhất là tiến công!
Sau khi trở về nước Anh, Fleming say sưa nghiên cứu những thứ thuốc tiêu diệt các loại vi khuẩn gây bệnh. Chính trong quá trình nghiên cứu này ông đã hắt hơi! Và đã khám phá ra lizozim - một thứ men giết chết vi khuẩn mà không gây tổn hại cho các mô khỏe mạnh. Các đối cực gặp nhau! Té ra là chính bản thân cơ thể lại sản sinh ra những chất mà nhà vi trùng học đang tìm kiếm khắp nơi. Nhưng đáng tiếc là lizozim không giúp đỡ gì trong cuộc đấu tranh chống các loài vi khuẩn nguy hiểm.
Bát nuôi cấy vi khuẩn của Fleming
Fleming bèn quyết định đi tìm trong cơ thể những nguồn dự trữ tiềm ẩn. Ông lấy vỏ chanh xát vào mắt, làm cho nước mắt chảy ra rồi hứng vào cái bát có chứa vi khuẩn. Hiệu quả thấy ngay tức khắc, nhưng rất yếu ớt. Những cuộc thí nghiệm được tiếp tục và ông đã có được một phát hiện sau đây. Còn ngẫu nhiên hơn.
Một lần ông đặt mấy cái bát có chứa chút canh thịt đã được khảo sát cạnh cửa sổ mở rộng và hai tuần sau thấy mốc đã xuất hiện trong một cái bát. Và không tìm thấy vi khuẩn trong canh thịt nữa.
Thật là một sự trùng hợp đáng ngạc nhiên! Vấn đề là cần phải làm sao cho trong bát có thứ mốc thuộc loại khá hiếm hoi là Penicilium Notatum mà người ta đang nghiên cứu trong các phòng thí nghiệm ở tầng dưới. Cửa sổ cần phải được mở ra để các bào tử mảnh mai theo gió bay vào bát canh thịt. Và nhiệt độ lúc đầu cần phải hạ xuống để cho mốc sinh sôi nảy nở. Còn sau đó nhiệt độ cần được tăng lên đúng lúc để vi khuẩn bị tiêu diệt. Ngoài ra, cần có một khoảng thời gian tương đối để mốc sản sinh ra một lượng penicillin cần thiết, để hợp dịch này thu hút được sự chú ý của nhà khoa học thực thụ.
Một sự kết hợp kỳ diệu không thể ngờ tới của những điều kiện cần thiết!
![]() |
Bát nuôi cấy vi khuẩn của Fleming |
Song, sau một lần dùng penicillin vào việc cứu chữa không thành công cho một cảnh sát bị chớm nhiễm trùng máu, Fleming ngộ ra rằng chỉ có thể dùng penicillin để điều trị các vết thương bên ngoài, rằng nó, cũng yếu như lizozim, ít có tác dụng chống lại các căn bệnh nguy hiểm. Và như vậy, công việc mới chỉ là bắt đầu. Phòng thí nghiệm chất đầy những cái ang lớn chứa vỏ của đủ loại hoa quả đã thối rữa mà trên đó khuẩn lạc của mốc penicillin phát triển rất tốt. Fleming đã phân phát cho bạn bè và người quen chất sát trùng đã thu lượm được như là một loại thuốc chống các vết xây xát và thậm chí ông còn dùng thứ mốc chữa bệnh để vẽ tranh!
Các vi khuẩn khác nhau được nhuộm bằng những màu khác nhau, thường là rất sặc sỡ. Fleming đã dùng chúng để làm màu vẽ. Muốn cho những "sắc tố" sống động ấy không bò lan sang những khu vực lân cận của bức tranh và làm hỏng hình vẽ, ông đã dùng penicillin bôi lên những đường ranh giới giữa các đốm màu và trưng bày những bức tranh ấy trong câu lạc bộ những người yêu nghệ thuật ở Chelsea.
Fleming nói rằng ông thấy mình hao hao giống các nhân vật trong truyện Đảo giấu vàng của nhà văn Stevenson: đã có tấm bản đồ của hòn đảo, địa điểm kho báu cũng đã tìm ra, thậm chí vài đồng tiền cổ đã được moi lên, nhưng kho báu vẫn chẳng thấy đâu.
Và lại có thêm một sự trùng hợp nữa. Một cô nhân viên phòng thí nghiệm đang định đem mấy chai "nước bẩn màu nhiệm" đi đổ thì gặp hai nhà vi trùng học đang tiếp tục nghiên cứu lizozim là Howard Walter Florey và Ernst Boris Chain. Hai ông bèn ngăn lại và đem mấy chai đó về phòng thí nghiệm của mình. Và họ đã lập tức thực hiện cái việc mà không hiểu tại sao Fleming chưa nghĩ ra: từ chỗ nước canh thịt ôi thiu lên mốc, hai ông đã chiết xuất tiêu bản, tinh chế rồi tiêm vào những con chuột mắc bệnh.
Kết quả thật kinh ngạc, hai ông chạy ngay đến chỗ Fleming. Ba nhà khoa học đã cùng nhau khử sạch tiêu bản, nghiên cứu nó bằng đủ mọi cách và sau một thời gian ngắn, thành phần hóa học của penicillin đã trở nên rõ ràng. Đó là một bước quan trọng để mở ra kho báu. Một khi biết được cấu tạo của chất thì có thể tìm ra những phương thức khai thác nó. Những chiếc thùng to chứa hoa quả thối rữa được thay bằng những tủ sấy nghiêm chỉnh, bằng những buồng khí kín; không khí được lọc sạch và bây giờ có thể đo đếm số lượng chất đã làm ra bằng những bao gói nặng hàng kilô.
Thành phố Oxford đã biến thành một công xưởng sản xuất penicillin. Nhu cầu vô cùng lớn. Chiến tranh đang diễn ra, cần phải cứu sống các thương binh khỏi chứng hoại thư, áp-xe, viêm phổi và vô số bệnh khác...
Năm 1944, cả ba nhà khoa học được Nữ hoàng Anh phong danh hiệu hiệp sĩ và trở thành nam tước.
Một năm sau, cả ba người được trao giải Nobel "Vì sự khám phá ra penicillin và tác động chữa bệnh của nó đối với các bệnh nhiễm khuẩn".
Trong lễ trao giải thưởng, nam tước Henri Gvaris, một trong những nhà vi trùng học vĩ đại nhất, đã nói: "Nếu không có Fleming thì sẽ không có cả Chain lẫn Florey. Nếu không có Chain thì sẽ không có Florey, còn nếu không có Florey thì chúng ta sẽ không có penicillin".
Những nhà khoa học lỗi lạc nhất trong lịch sử
Các nhà khoa học là những người rất quan trọng đối với nhân loại. Nhờ có những phát minh, công trình nghiên cứu của học mà thế giới mới phát triển như ngày nay.
“Truyền nhân” của nhà tiên tri Vanga dự đoán gì đầu tiên?
Nhà tiên tri nổi tiếng Vanga qua đời năm 1996, nhưng trước khi về "thế giới bên kia", bà đã kịp đề cập đến "truyền nhân" của mình. Và giờ đây, người đó đã xuất hiện...
Những cái chết bi thảm của người "không tin" lời nhà tiên tri mù Vanga
Nhà tiên tri Vanga đã tiên đoán rất nhiều sự việc đau thương nhưng không thể ngăn chặn điều đó xảy ra với gia đình mình.
Cuộc đời dị thường của nhà khoa học Nikola Tesla
Trong lịch sử, chúng ta luôn ghi nhận Thomas Edison là nhà phát minh vĩ đại nhất trừ trước đến giờ tuy nhiên ngay trong thời đại của ông cũng có một nhà phát minh tài năng không kém. Đó chính là Nikola Tesla.
Acsimet - nhà bác học vĩ đại của Hy Lạp cổ
Archimedes của Syracuse là một nhà toán học, nhà vật lý, kỹ sư, nhà phát minh, và một nhà thiên văn học người Hy Lạp. Dù ít chi tiết về cuộc đời ông được biết, ông được coi là một trong những nhà khoa học hàng đầu của thời kỳ cổ đại.
Những thiên tài tự học "đỉnh" nhất mọi thời đại
Họ đều có điểm chung là không có điều kiện để được học hành đầy đủ nhưng bằng chính sự đam mê, ham học hỏi đã giúp họ thành công và nổi danh.